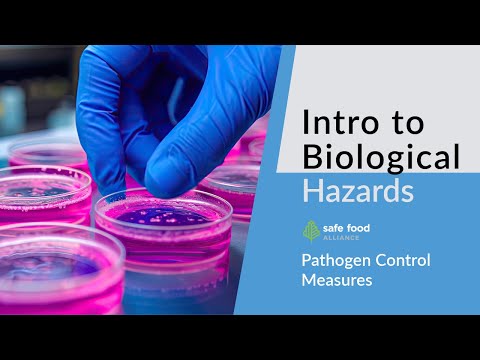
HACCP 101: Biological Pathogen Control Measures | Food Safety Training

Biological hazards are a major concern in the food industry, posing serious risks to public health and safety. From foodborne illnesses to contamination outbreaks, the consequences can be devastating. As a food safety expert, you know that preventing biological hazards requires a multifaceted approach, involving proper training, equipment, and protocols. In this comprehensive guide, we’ll delve into the key principles of food safety, explore common biological hazards, and provide actionable tips for maintaining a clean and sanitized kitchen environment. Whether you’re a food establishment owner, operator, or employee, this guide will equip you with the knowledge and tools to prevent biological hazards and ensure a safe food handling environment for your customers.
🔑 Key Takeaways
- Wash your hands frequently, especially after using the restroom, before handling food, and after touching raw meat, poultry, or seafood.
- Store perishable foods at a temperature of 40°F (4°C) or below to prevent bacterial growth.
- Prevent cross-contamination by separating raw and ready-to-eat foods, using separate cutting boards and utensils, and cleaning and sanitizing equipment regularly.
- Common biological hazards in the food industry include Salmonella, E. coli, and Listeria, which can be spread through contaminated food, water, or surfaces.
- Proper food storage and handling are crucial in preventing biological hazards, as they can help prevent bacterial growth and contamination.
- Employees play a vital role in preventing biological hazards by following proper food safety protocols, reporting any concerns or issues, and participating in regular training and audits.
The Importance of Hand Hygiene
Hand hygiene is a critical component of food safety, and it’s essential that employees wash their hands frequently, especially after using the restroom, before handling food, and after touching raw meat, poultry, or seafood. The Centers for Disease Control and Prevention (CDC) recommend washing hands with soap and water for at least 20 seconds, paying particular attention to areas between fingers, under nails, and the backs of hands. This simple yet effective practice can significantly reduce the risk of cross-contamination and foodborne illnesses.
Perishable Food Storage: A Temperature Control Primer
Proper storage of perishable foods is critical in preventing bacterial growth and contamination. The US Department of Agriculture (USDA) recommends storing perishable foods at a temperature of 40°F (4°C) or below to prevent bacterial growth. This includes foods such as meat, poultry, dairy products, and eggs. It’s essential to check storage temperatures regularly and ensure that refrigerators and freezers are functioning correctly. Additionally, consider investing in a temperature-controlled storage system to maintain optimal temperatures and prevent temperature fluctuations.
Preventing Cross-Contamination in the Kitchen
Cross-contamination is a common cause of foodborne illnesses, and it’s essential to take steps to prevent it in the kitchen. One effective way to prevent cross-contamination is to separate raw and ready-to-eat foods, using separate cutting boards and utensils for each. This includes separating raw meat, poultry, and seafood from ready-to-eat foods such as fruits and vegetables. Additionally, clean and sanitize equipment regularly, and ensure that employees are following proper food handling and preparation procedures.
Common Biological Hazards in the Food Industry
Biological hazards such as Salmonella, E. coli, and Listeria are common in the food industry and can cause serious health problems. These pathogens can be spread through contaminated food, water, or surfaces, and can be particularly problematic in high-risk foods such as raw meat, poultry, and seafood. It’s essential to take steps to prevent these hazards, including proper food handling and preparation, regular cleaning and sanitizing, and employee training and education.
The Role of Employees in Preventing Biological Hazards
Employees play a vital role in preventing biological hazards, and it’s essential that they follow proper food safety protocols, report any concerns or issues, and participate in regular training and audits. This includes following proper hand hygiene procedures, storing perishable foods at the correct temperature, and preventing cross-contamination in the kitchen. Additionally, employees should be aware of the common biological hazards in the food industry and take steps to prevent them, including proper food handling and preparation and regular cleaning and sanitizing.
Ensuring Employee Compliance with Food Safety Practices
Ensuring employee compliance with food safety practices is critical in preventing biological hazards. This includes providing regular training and education, conducting regular audits and inspections, and enforcing strict food safety protocols. Consider implementing a food safety management system, such as HACCP (Hazard Analysis and Critical Control Points), to help identify and prevent biological hazards. Additionally, provide incentives for employees who follow proper food safety procedures and penalize those who do not.
The Consequences of Failing to Prevent Biological Hazards
Failing to prevent biological hazards can have serious consequences, including foodborne illnesses, contamination outbreaks, and economic losses. In the United States alone, foodborne illnesses result in over 48 million cases of illness each year, with 128,000 hospitalizations and 3,000 deaths. The economic impact of these illnesses is estimated to be over $15 billion annually. It’s essential to take steps to prevent biological hazards, including proper food handling and preparation, regular cleaning and sanitizing, and employee training and education.
The Importance of Proper Handwashing in Preventing Biological Hazards
Proper handwashing is a critical component of food safety, and it’s essential that employees wash their hands frequently, especially after using the restroom, before handling food, and after touching raw meat, poultry, or seafood. The Centers for Disease Control and Prevention (CDC) recommend washing hands with soap and water for at least 20 seconds, paying particular attention to areas between fingers, under nails, and the backs of hands. This simple yet effective practice can significantly reduce the risk of cross-contamination and foodborne illnesses.
Maintaining a Clean and Sanitized Kitchen Environment
Maintaining a clean and sanitized kitchen environment is critical in preventing biological hazards. This includes regular cleaning and sanitizing of equipment, utensils, and surfaces, as well as proper disposal of waste and cleaning of floors and drains. Consider implementing a cleaning schedule, including daily, weekly, and monthly tasks, to ensure that the kitchen environment remains clean and sanitized. Additionally, provide employees with the necessary cleaning supplies and equipment to maintain a clean and sanitized environment.
The Benefits of Food Safety Training for Employees
Food safety training is essential for employees in the food industry, providing them with the knowledge and skills to prevent biological hazards and maintain a safe food handling environment. This training should cover topics such as proper hand hygiene, food storage and handling, cross-contamination prevention, and cleaning and sanitizing procedures. Additionally, consider providing ongoing training and education to employees to ensure that they stay up-to-date on the latest food safety protocols and procedures.
The Key Principles of Food Safety at StateFoodSafety
The key principles of food safety at StateFoodSafety include proper hand hygiene, food storage and handling, cross-contamination prevention, and cleaning and sanitizing procedures. Additionally, employees should be aware of the common biological hazards in the food industry and take steps to prevent them, including proper food handling and preparation and regular cleaning and sanitizing. By following these key principles, employees can help prevent biological hazards and maintain a safe food handling environment for customers.
❓ Frequently Asked Questions
What are some common mistakes that employees make when handling food that can lead to biological hazards?
Common mistakes that employees make when handling food include not washing hands frequently, not separating raw and ready-to-eat foods, and not cleaning and sanitizing equipment regularly. Additionally, employees may not follow proper food storage and handling procedures, which can lead to bacterial growth and contamination. To prevent these mistakes, consider providing regular training and education to employees, as well as implementing a food safety management system such as HACCP.
How can I ensure that my employees are following food safety procedures in the kitchen?
To ensure that employees are following food safety procedures in the kitchen, consider implementing a food safety management system such as HACCP. Additionally, provide regular training and education to employees, and conduct regular audits and inspections to ensure compliance. Consider also implementing a system of incentives and penalties to encourage employees to follow food safety procedures.
What are some common biological hazards that can be spread through contaminated food or surfaces?
Common biological hazards that can be spread through contaminated food or surfaces include Salmonella, E. coli, and Listeria. These pathogens can be particularly problematic in high-risk foods such as raw meat, poultry, and seafood, and can cause serious health problems if ingested. To prevent these hazards, consider implementing proper food handling and preparation procedures, regular cleaning and sanitizing, and employee training and education.
How can I maintain a clean and sanitized kitchen environment?
To maintain a clean and sanitized kitchen environment, consider implementing a cleaning schedule, including daily, weekly, and monthly tasks. Additionally, provide employees with the necessary cleaning supplies and equipment to maintain a clean and sanitized environment. Consider also implementing a system of incentives and penalties to encourage employees to maintain a clean and sanitized kitchen environment.
What are some tips for preventing cross-contamination in the kitchen?
To prevent cross-contamination in the kitchen, consider separating raw and ready-to-eat foods, using separate cutting boards and utensils for each. Additionally, clean and sanitize equipment regularly, and ensure that employees are following proper food handling and preparation procedures. Consider also implementing a system of incentives and penalties to encourage employees to prevent cross-contamination.
How can I ensure that my employees are aware of the importance of food safety and the role they play in preventing biological hazards?
To ensure that employees are aware of the importance of food safety and the role they play in preventing biological hazards, consider providing regular training and education to employees. Additionally, consider implementing a system of incentives and penalties to encourage employees to follow food safety procedures. Consider also conducting regular audits and inspections to ensure compliance, and providing ongoing training and education to employees to ensure that they stay up-to-date on the latest food safety protocols and procedures.